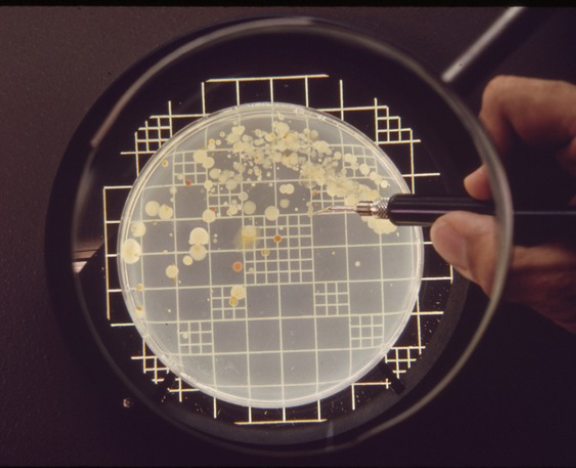

-
-
-
Tổng tiền thanh toán:
-
Precisa- Hãng cân hàng đầu thế giới đến từ Thụy Sỹ
An Hòa
13/02/2023
Kể từ năm 1935, Precisa đã phát triển và sản xuất những chiếc cân và thiết bị tốt nhất thuộc loại này trên thế giới. Với chất lượng và độ chính xác nổi tiếng của Thụy Sĩ, Precisa được công nhận trên toàn cầu là một trong những công ty sản xuất cân hàng đầu. Mạng lưới phân phối toàn cầu tại...